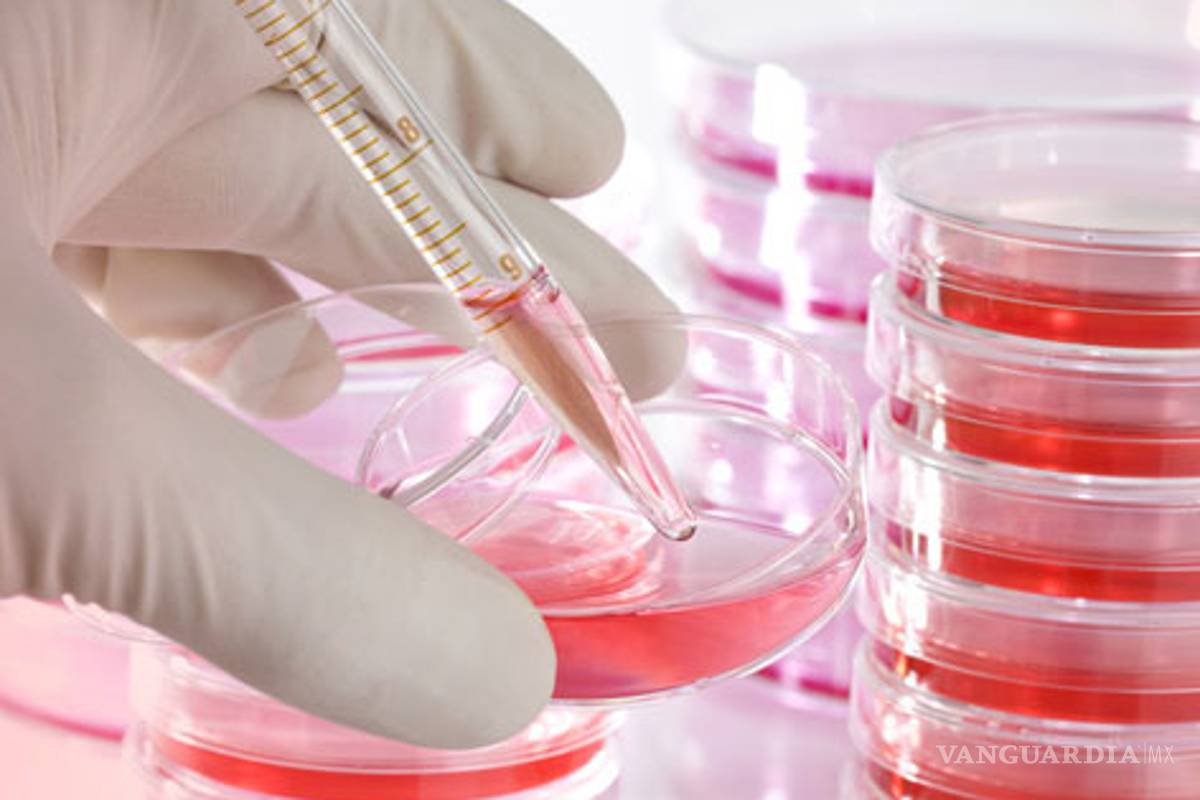
Impulsan en México estudio con células madre dentales

Impulsan en México estudio con células madre dentales
COMPARTIR
Bioeden México preserva las células criogénicamente para utilizarlas contra enfermedades. El pasado 5 de julio se realizó el primer trasplante de células de ese tipo, extraídas de las muelas del juicio
México.- Empresas científicas impulsan en México protocolos de experimentación con células madres dentales, con el fin de avanzar en los tratamientos y curación de diversas enfermedades mediante métodos que parecen de ciencia ficción.
En entrevista Víctor Saadia, director de Operaciones de Bioeden México, informó que es un banco de células madre dentales, que las preserva criogénicamente, es decir las congelan con el vapor de nitrógeno líquido a menos 150 grados centígrados.
Expuso que se apoya la investigación científica con células madres de dientes en el país en instituciones públicas como el Hospital Juárez de México, donde hace un año, el 5 de julio, se realizó el primer trasplante de células de ese tipo, extraídas de las muelas del juicio.
De esta manera "se ayudó a regenerar el hueso de la mandíbula a un joven de 16 años con problemas de quistes y tumores en la cara. Este innovador procedimiento se ha realizado con éxito en otros países del mundo", comentó el ingeniero Saadia.
Recordó que en este hecho sin precedentes participaron los doctores Rodrigo Licéaga, cirujano maxilofacial del Hospital Juárez de México, y Raúl Rosales Ibáñez, profesor-investigador del Laboratorio de Ciencias Básicas e Ingeniería Tisular de la Universidad Autónoma de San Luis Potosí.
Añadió que otro protagonista de este importante acontecimiento de la medicina en México fue Marc Saadia, director de Investigación de Bioeden México, y destacó que "tratamos de desarrollar en México protocolos experimentales para desarrollar nuevos tratamientos, la demanda por tratamientos es muy alta, las células madres prometen demasiado".
Víctor Saadia dio a conocer que trabajan con el Instituto Nacional de Rehabilitación (INR) de la Secretaría de Salud (SSA), con el doctor Clemente Ibarra, quien lleva 12 años investigando con células madres en el tratamiento de menisco, así como de rodilla y articulaciones.
"Estamos empezando a ver la manera de desarrollar un protocolo para tratar pacientes con células madres de los dientes. Todo se ve muy prometedor y a partir de lo que se hizo en el Hospital Juárez empezamos a abrir nuevas fronteras y en ese sentido la visión de Bioeden México es doble", destacó.
En este contexto, sostuvo que la misión que tienen es acercar la medicina regenerativa a los mexicanos, por un lado preservando las células madres de los dientes y por otro promoviendo la investigación e información sobre este tema.
Es decir, se busca promover el interés de las instituciones y de la opinión pública, a través del conocimiento de estos avances científicos que se comparan con hechos de ciencia ficción, como sucedió el siglo pasado cuando se hablaba de trasplantar un órgano vital como corazón, hígado, pulmón o riñones, incluso una transfusión de sangre era vista como un hecho irreal.
"Antes en el pasado una vacuna nueva, un antibiótico y un trasplante se tornaba increíble,eran cosas que sonaban de ciencia ficción y la gente era muy escéptica", comentó el ejecutivo de Bioeden.
Afirmó que la medicina regenerativa está en ese punto, mucha gente sabe que es la realidad, aunque hay escépticos, no creen que se pueda producir un órgano como un riñón, o un corazón, "pero dentro de 10 años más será de todos los días y la medicina regenerativa seguirá abriendo fronteras".
Por lo anterior, invitó a las personas a sumarse a ese esfuerzo, a fin de que "las células madres dentales crezcan, que las guarden, que las preserven, sólo tienen que guardar los dientes de leche y aquí les decimos cómo".
El especialista insistió en que es importante tener conciencia de la importancia de las células madre de los dientes, saber que es una fuente abundante de células y que tienen potencialidad para tratar muchas enfermedades.
Explicó que conforme aumenta la edad se pierden las células madres y por ello es que hay más en tejidos de niños y jóvenes, es por ello que los dientes de leche las tienen y se pueden extraer, para conservarse en temperaturas de menos de 150 grados centígrados lo que garantiza su preservación por más de 40 años.
"En los años 60 se descubrieron células madres en la médula ósea, que tiene dos capacidades a diferencia de las demás del cuerpo, primero es que se puede autorenovar, es decir se multiplica y proliferan", informó Víctor Saadia.
La segunda propiedad que tiene, precisó, es que se pueden diferenciar distintos tipos de tejido, es decir se pueden convertir en una célula de hueso, de corazón, de piel o neural.
"Tenemos dos tipos de célula madre, (unas son) las que pueden realizar todos los tejidos del cuerpo humano, pero el problema es que son las células embrionarias y son difíciles de obtener".
El experto refirió que las que ellos trabajan son las células madre adultas, multipotenciales, que no pueden formar todos los tejidos del cuerpo, sólo algunos, y dentro de esa línea hay dos tipos, las del cordón umbilical y las de los dientes.
Explicó que las células madres del cordón umbilical se denominan hematopoyéticas, son de la línea sanguínea, y pueden llegar a tratar enfermedades de la sangre como leucemias, linfomas y anemias, y actualmente hay más de 70 enfermedades que ya se tratan con ellas.
Las células de los dientes y de la médula ósea son de otro tipo, se llaman mesenquimales que se pueden usar para enfermedades cardiacas, mal de Parkinson y Alzheimer, así como diabetes, parálisis por lesiones en médula espinal, y reproducir hueso y cartílago.
"Son células que se pueden convertir en huesos, músculos, piel, corazón, células cardiacas, hepáticas (hígado), células nerviosas, pancreáticas, de córnea, entre otras", específico el ejecutivo de Bioeden.
En el caso de las células de los dientes mencionó que "el laboratorio toma el diente de leche, saca la pulpa dental, separa las células madres y se ponen en un cultivo, que es líquido proteínico que le va a dar de comer a la célula para que crezca, y de una célula se hacen dos, luego cuatro y hasta el infinito", concluyó.








